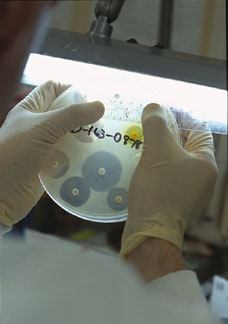
Εργαστήριο - τριβλίο petri

Home
Ευρωπαϊκή Έρευνα & Ανάπτυξη
- Λεπτομέρειες
- Γράφτηκε από τον/την Παναγιώτης Στασινάκης
- Κατηγορία: Επιστημονικές Ειδήσεις
- Εμφανίσεις: 4483
 Σύμφωνα με τα αποτελέσματα έρευνας που έγινε από την Eurostat (The Statistical Office of the European Communities) και παρουσιάστηκαν στις αρχές του Νομέμβρη, οι δαπάνες για την Έρευνα και την Ανάπτυξη αυξήθηκαν το 1999 και 2000.
Σύμφωνα με τα αποτελέσματα έρευνας που έγινε από την Eurostat (The Statistical Office of the European Communities) και παρουσιάστηκαν στις αρχές του Νομέμβρη, οι δαπάνες για την Έρευνα και την Ανάπτυξη αυξήθηκαν το 1999 και 2000.
Ο ερευνητής και ο ρόλος του στη σημερινή κοινωνία
- Λεπτομέρειες
- Γράφτηκε από τον/την Κωνσταντίνος Κουκάρας
- Κατηγορία: Επιστημονικές Ειδήσεις
- Εμφανίσεις: 16771
 Ο διεθνώς αποδεκτός ορισμός της έρευνας με βάση το εγχειρίδιο Frascati είναι: "Έρευνα και πειραματική ανάπτυξη συνιστά η δημιουργική εργασία που επιτελείται σε συστηματική βάση ούτως ώστε να αυξηθεί το επίπεδο της γνώσης, όπου συμπεριλαμβάνεται η γνώση του ανθρώπου, του πολιτισμού και της κοινωνίας και η χρήση αυτού του αποθέματος γνώσης για την εκπόνηση νέων εφαρμογών". Κατά συνέπεια, οι ερευνητές περιγράφονται ως: "Επαγγελματίες που καταγίνονται με τη σύλληψη της ιδέας ή τη δημιουργία νέας γνώσης, προϊόντων, διαδικασιών μεθόδων και συστημάτων και τη διαχείριση των αντιστοίχων έργων".
Ο διεθνώς αποδεκτός ορισμός της έρευνας με βάση το εγχειρίδιο Frascati είναι: "Έρευνα και πειραματική ανάπτυξη συνιστά η δημιουργική εργασία που επιτελείται σε συστηματική βάση ούτως ώστε να αυξηθεί το επίπεδο της γνώσης, όπου συμπεριλαμβάνεται η γνώση του ανθρώπου, του πολιτισμού και της κοινωνίας και η χρήση αυτού του αποθέματος γνώσης για την εκπόνηση νέων εφαρμογών". Κατά συνέπεια, οι ερευνητές περιγράφονται ως: "Επαγγελματίες που καταγίνονται με τη σύλληψη της ιδέας ή τη δημιουργία νέας γνώσης, προϊόντων, διαδικασιών μεθόδων και συστημάτων και τη διαχείριση των αντιστοίχων έργων".
Περισσότερα: Ο ερευνητής και ο ρόλος του στη σημερινή κοινωνία
Οι ερευνητές αγωνιούν για την περίπτωση χρήσης των αποτελεσμάτων τους από εγκληματίες
- Λεπτομέρειες
- Γράφτηκε από τον/την Παναγιώτης Στασινάκης
- Κατηγορία: Επιστημονικές Ειδήσεις
- Εμφανίσεις: 8443
Πώς μπορούν οι ερευνητές των βιοεπιστημών να διαβεβαιώσουν πως τα αποτελέσματά τους δεν θα χρησιμοποιηθούν με άσχημο τρόπο από ομάδες εγκληματιών; Επιτροπή της αμερικάνικης κυβέρνησης έχει καταλήξει σε κάποια ευρεία απάντηση σχετικά με την ερώτηση και έχει προτείνει ότι σε μερικές περιπτώσεις οι επιστήμονες δεν θα πρέπει να δημοσιεύουν τα αποτελέσματα ερευνών που μπορεί να τυγχάνουν "διπλής χρήσης". Η 25μελής επιτροπή - Εθνική Συμβουλευτική Επιτροπή Επιστημών για τη Βιοπροστασία (National Science Advisory Board for Biosecurity - NSABB) - ιδρύθηκε από το τμήμα Υγείας και Ανθρωπίνων Υπηρεσιών πριν από δύο χρόνια για να βοηθήσει την κυβέρνηση να αναπτύξει μέτρα προστασίας ενάντια στην αδικαιολόγητη εφαρμογή της έρευνας των βιολογικών επιστημών.
Πώς μπορούν οι ερευνητές των βιοεπιστημών να διαβεβαιώσουν πως τα αποτελέσματά τους δεν θα χρησιμοποιηθούν με άσχημο τρόπο από ομάδες εγκληματιών; Επιτροπή της αμερικάνικης κυβέρνησης έχει καταλήξει σε κάποια ευρεία απάντηση σχετικά με την ερώτηση και έχει προτείνει ότι σε μερικές περιπτώσεις οι επιστήμονες δεν θα πρέπει να δημοσιεύουν τα αποτελέσματα ερευνών που μπορεί να τυγχάνουν "διπλής χρήσης". Η 25μελής επιτροπή - Εθνική Συμβουλευτική Επιτροπή Επιστημών για τη Βιοπροστασία (National Science Advisory Board for Biosecurity - NSABB) - ιδρύθηκε από το τμήμα Υγείας και Ανθρωπίνων Υπηρεσιών πριν από δύο χρόνια για να βοηθήσει την κυβέρνηση να αναπτύξει μέτρα προστασίας ενάντια στην αδικαιολόγητη εφαρμογή της έρευνας των βιολογικών επιστημών.
Περισσότερα: Οι ερευνητές αγωνιούν για την περίπτωση χρήσης των αποτελεσμάτων τους από εγκληματίες
Θαμμένοι λόφοι άλατος
- Λεπτομέρειες
- Γράφτηκε από τον/την Παναγιώτης Στασινάκης
- Κατηγορία: Επιστημονικές Ειδήσεις
- Εμφανίσεις: 2600

Η διαχείριση των αλάτων, τον τελευταίο καιρό έχει αναδειχθεί σε μείζον πρόβλημα, μετά και από την ανακάλυψη αρχαίων ποτάμϊων πυθμένων, που περιέχουν αλμυρό νερό κρυμμένο κάτω από την επιφάνεια της σύγχρονης Αυστραλίας. Η τεχνολογία που χρησιμοποιήθηκε για τον εντοπισμό και μετέπειτα την εξερεύνηση, έχει αποκαλύψει για πρώτη φορά ένα κρυμμένο στρώμα βράχων
Σελίδα 36 από 75
